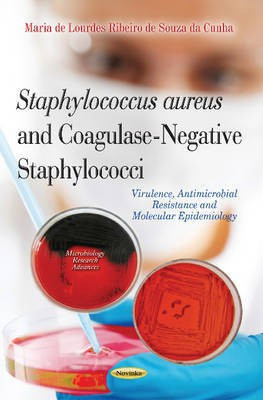

Staphylococcus Aureus & Coagulase-Negative Staphylococci(English, Paperback, Maria de Lourdes Ribeiro de Souza da Cunha Maria de)
Quick Overview
Product Price Comparison
The book covers updated topics on the genus Staphylococcus, including the latest discoveries. In each chapter, the author discusses the results obtained and published during her 20-plus years as a researcher in this area. The book is divided into eight chapters, with a presentation of the genus Staphylococcus, current classification, general characteristics of these bacteria and the clinical significance of coagulase-negative staphylococci (CoNS), which are often classified as mere blood culture contaminants, but are the etiological agents most commonly associated with neonatal infections and peritonitis in patients undergoing peritoneal dialysis. Coagulase-negative staphylococci can colonize the surface of catheters and produce an extracellular polysaccharide that leads to the formation of biofilms which potentiate their pathogenicity. The book also focuses on the identification of CoNS, virulence factors responsible for the symptoms and severity of infections caused by Staphylococcus spp. These factors include membrane-active toxins, called cytotoxins, and a group of pyrogenic toxin superantigens. Several current aspects related to the virulence of S. aureus and CoNS are discussed, including isolates of different origins, phenotypic and genotypic techniques for the detection of these toxins, and the gene regulation mechanism involved in the expression of these toxins. Another extremely important topic which is discussed is the resistance of these microorganisms to antimicrobial agents. MRSA currently represent a serious threat to public health worldwide due to the rapid dissemination and diversification of pandemic clones. The epidemiology of MRSA infections is discussed highlights the importance of understanding why specific clones predominated in different regions in order to develop more effective control strategies and to choose more appropriate antimicrobial therapy. In this book, the topics are explained in a clear and objective manner and should be useful for postgraduate students, physicians and researchers.